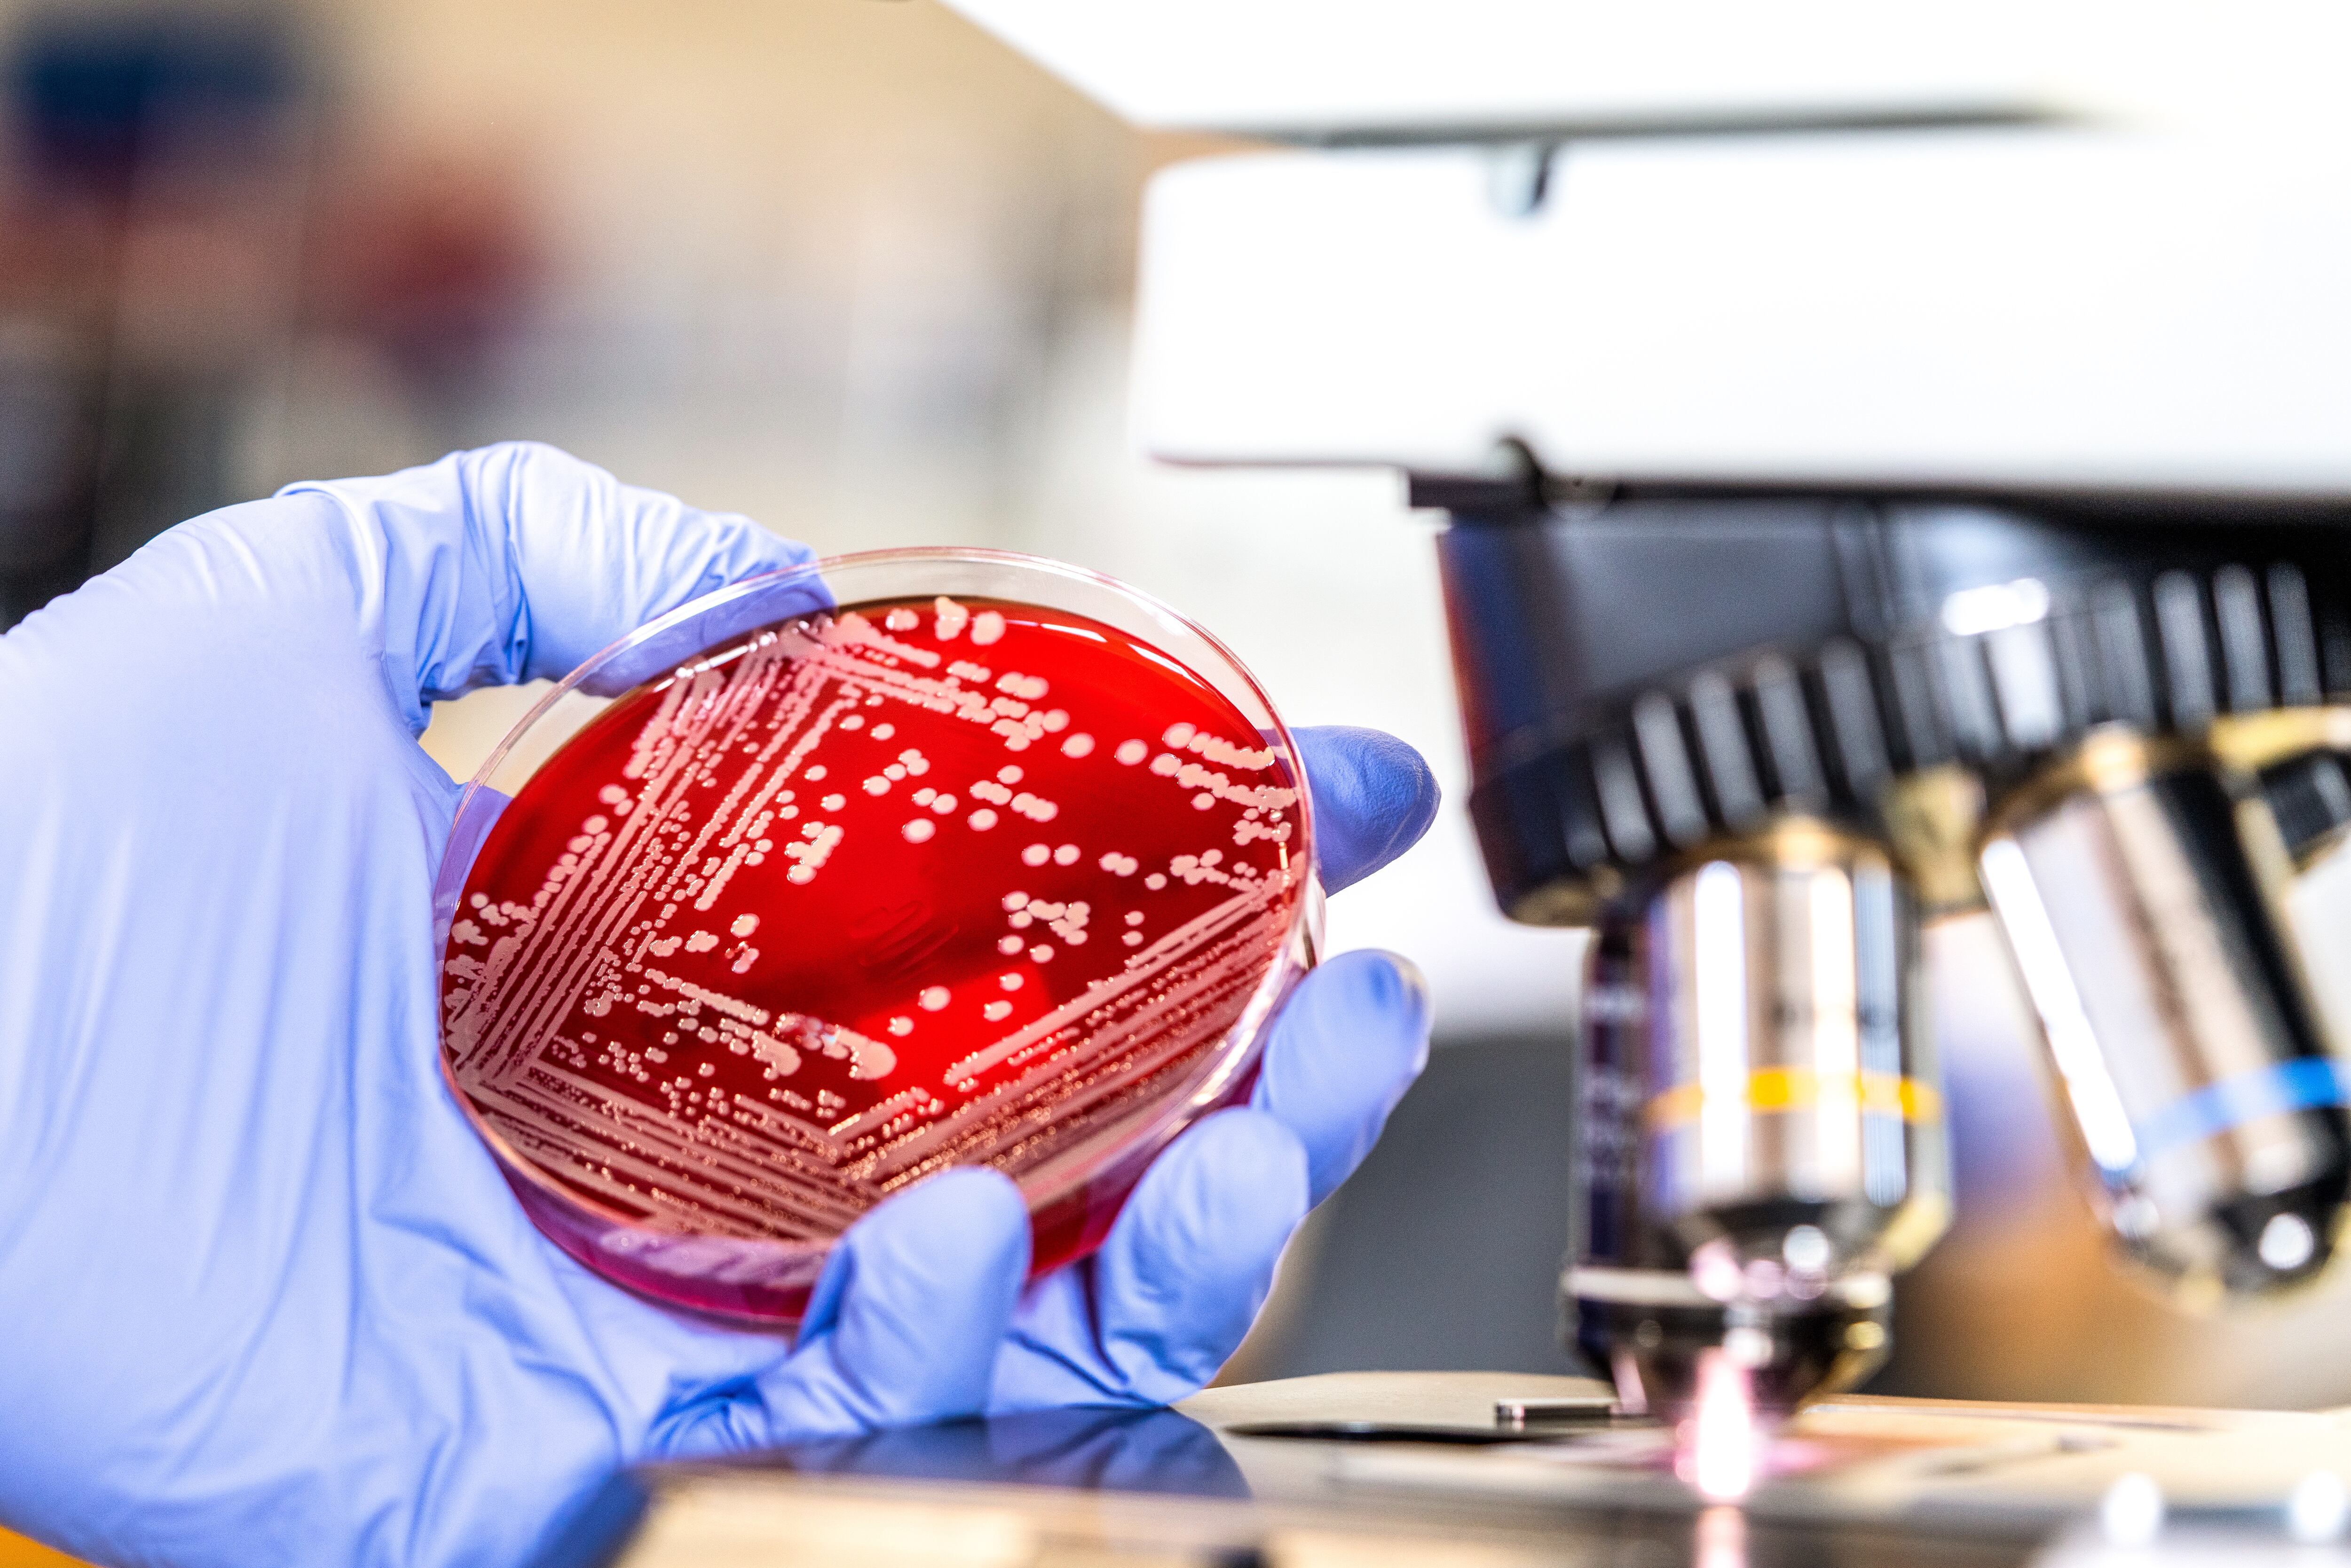
Septicemia

Un estudio realizado por especialistas de la Universidad de Washington revelaron que hay una enfermedad que es silenciosa, y acaba con la vida de más de 11 millones de personas. Se trata de la septicemia, una afección grave, según Mayo Clinic, entidad sin ánimo de lucro dedicada a la práctica clínica, la educación y la investigación, en la que el cuerpo responde de manera incorrecta a una infección.
“En el pasado, la septicemia se conocía comúnmente como “toxemia”; casi siempre era mortal. Hoy en día, incluso con tratamiento anticipado, la septicemia mata aproximadamente a una de cada cinco personas infectadas”, explicaron los Institutos Nacionales de Salud de Estados Unidos (NIH, por sus siglas en inglés).

Respecto a los síntomas, la entidad sin ánimo de lucro indicó que pueden incluir los siguientes:
- Cambio en el estado mental.
- Respiración superficial y rápida.
- Sudoración sin motivo aparente.

- Aturdimiento.
- Escalofríos.
- Síntomas específicos al tipo de infección, como micción dolorosa cuando hay una infección de las vías urinarias o tos que empeora cuando hay neumonía.
No obstante, es importante señalar que los síntomas de la septicemia no son específicos, y pueden variar de una persona a otra, y la afección puede aparecer de forma diferente en los niños y los adultos.
Entre tanto, los NIH indicaron que cualquier persona puede sufrir una septicemia, pero los adultos mayores, los niños y los lactantes son los más vulnerables. Asimismo, las personas con sistemas inmunitarios debilitados, quemaduras graves, traumatismos físicos o enfermedades prolongadas (como diabetes, cáncer o enfermedad hepática) también corren riesgos mayores.
¿Qué causa septicemia?
Según Mayo Clinic todo tipo de infección puede derivar en septicemia. Esto incluye infecciones bacterianas, virales o micóticas, y las infecciones más comunes que derivan en septicemia incluyen las siguientes:

- Riñón, vejiga y otras partes del sistema urinario.
- Aparato digestivo.
- Torrente sanguíneo.
- Lugares de colocación de catéter.
- Heridas o quemaduras.
“Con la septicemia, la lucha entre la infección y la respuesta inmune del cuerpo convierte al cuerpo en un campo de batalla”, explicó el Dr. Derek Angus, médico terapista de la Facultad de Medicina de la Universidad de Pittsburgh (University of Pittsburgh School of Medicine). “En los casos de septicemia grave, esa lucha provoca el mal funcionamiento de órganos vitales, lo cual pone en peligro la vida de uno”, agregó.
De hecho, hay que indicar que a medida que la septicemia empeora, los órganos vitales, como el cerebro, el corazón y los riñones, no reciben la cantidad de sangre que deberían.

De todos modos, la información antes dada de ninguna manera sustituye la asesoría médica y por ello, lo primero que hay que hacer es consultar a un experto de la salud.
Referencias
- Septicemia - Mayo Clinic, entidad sin ánimo de lucro dedicada a la práctica clínica, la educación y la investigación
- Cómo sobrevivir a la septicemia - Institutos Nacionales de Salud de Estados Unidos
